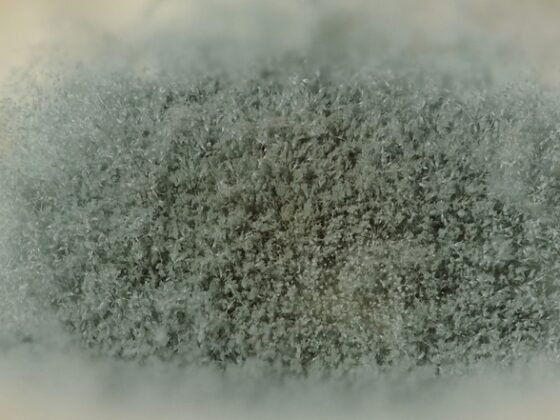
featured image - Do I Really Need Mold Remediation

Table of Contents Show
Complement your apartment by choosing the best awning with these tips!
Retractable awnings are unique features that can transform and beautify your apartment. They are additional means of making the outdoor space of your apartment lively and welcoming.
With awnings, you’ve found yourself a place to relax in the summer sun, have an evening get-together with friends and family, and technically rest after a long day at work.
And a fantastic thing about awnings is that they remain functional ALL YEAR ROUND regardless of the weather condition.
So, if you decide to install a retractable awning in your apartment’s outdoor space, you need to go about it strategically.
There are some things you need to consider while picking the best awning for you. You shouldn’t go ahead and buy one without considering these factors.
They will determine the choice of awning that is best for you. Take a look at these factors;

The Suitable Material
As always, the materials and fabrics of the retractable awnings will play a significant role in its durability.
Different materials will require an extra level of maintenance and another suiting to the outdoor space.
The most common materials used in making retractable awnings are outdoor fabrics (polyester, vinyl, or acrylic) or metals (aluminum). Awnings could also be made from natural materials like canvas or wood.
Fabric materials require more maintenance than metals and will tend to wear out more quickly.
However, they are the most versatile and easiest to customize. Unlike fabric awnings, aluminum is sturdier and more resistant, but they do not permit customization in designs, colors, and patterns.
Side Panels
Side panels are additional features that can drastically change the appearance of the awnings and make them feel more like an architectural structure.
You may choose to add this feature to your awning. Side panels will provide additional coverage from the sun and rain.
It could be extended to different directions when a shade is required. This feature is a common one for homeowners using retractable awnings.
Read Also:
The Awning Size -Large or Small?
The size of the retractable awning will depend on the purpose, location, and size of your outdoor space.
Do you want a big or small awning? That will depend on why you need the awning, the area you intend to create, and where it will be mounted.
Small awnings are primarily used as decorative features and usually don’t create more shade or space.
Meanwhile, larger awnings, otherwise called Shades awnings, will provide more coverage and shade to your area.
The Angle of the Awning
This factor is mainly overlooked, and it shouldn’t be that way. It will play a massive role in the general performance and functionality of the awning.
For windows at the east or west cardinals, it would be best to drop the size to 65% or 75% to gain optimal functionality.
For windows facing south, the drop should be 45% or 50% because less protection from the sun is needed from that angle (the same applies to a window facing northwards)
The Color and Style
Without much deliberation, this should be well understood. The colors will affect the fade-resistance of the awning. Dark colors will increase the temperature underneath the awning.
Bright colors will fade quickly, while neutral colors will last longer and seamlessly fit most house architectural perspectives.
There are different styles to choose from. Some popular ones include dome-style, waterfall, or semi-circular awnings. Whichever works, depending on the site, it is mounted.
Awnings remain unique features to add to your home, and for you to gain the full advantage, you need to choose wisely!